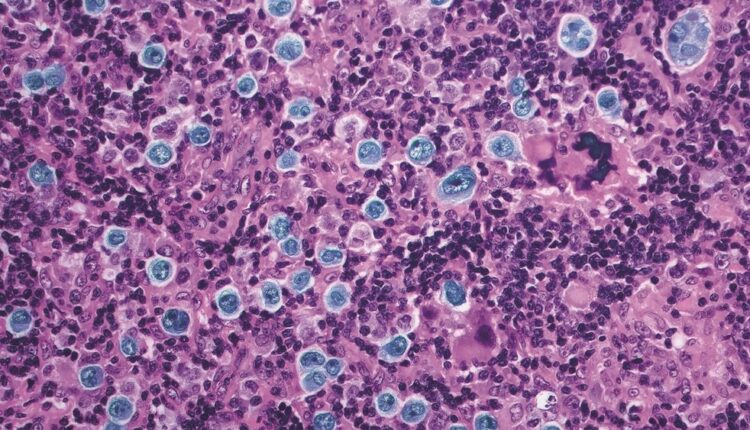

Μέσα σε κάθε μορφή καρκίνου υπάρχουν μόρια που διεγείρουν τη θανατηφόρα, ανεξέλεγκτη ανάπτυξη. Τι θα γινόταν αν οι επιστήμονες μπορούσαν να συνδέσουν αυτά τα μόρια με άλλα, που κάνουν τα κύτταρα να αυτοκαταστρέφονται; Θα μπορούσαν οι ίδιοι οι οδηγοί της ανάπτυξης ενός καρκίνου να ενεργοποιήσουν το πρόγραμμα για την καταστροφή του;
Αυτή η ιδέα ήρθε ξαφνικά στον Δρα Gerald Crabtree, αναπτυξιακό βιολόγο στο Stanford, πριν από μερικά χρόνια, κατά τη διάρκεια μιας βόλτας κοντά στο σπίτι του στα βουνά Santa Cruz. “Έτρεξα σπίτι”, είπε, “ενθουσιασμένος με την ιδέα, και ξεκίνησα να σχεδιάζω τρόπους να το κάνω να λειτουργήσει”.
Τώρα, σε μια εργασία που δημοσιεύτηκε στις 26 Ιουλίου στο περιοδικό “Nature”, ο Crabtree, ιδρυτής της Shenandoah Therapeutics, η οποία αναπτύσσει φάρμακα για τον καρκίνο, μαζί με τον Nathanael Gray, καθηγητή χημείας και βιολογίας συστημάτων στο Stanford, και τους συναδέλφους τους αναφέρουν ότι έχουν πραγματοποιήσει αυτό που είχε φανταστεί σε εκείνη τη βόλτα. Ενώ η ιδέα απέχει πολύ από ένα φάρμακο που θα μπορούσε να χορηγηθεί σε ασθενείς με καρκίνο, θα μπορούσε να αποτελέσει στόχο για τους κατασκευαστές φαρμάκων στο μέλλον.
“Είναι πολύ κουλ”, είπε ο Jason Gestwicki, καθηγητής φαρμακευτικής χημείας στο Πανεπιστήμιο της Καλιφόρνιας στο Σαν Φρανσίσκο. “Μετατρέπει κάτι που χρειάζεται το καρκινικό κύτταρο για να παραμείνει ζωντανό σε κάτι που το σκοτώνει, σαν να αλλάζατε τη βιταμίνη σας με δηλητήριο”.
Ο Δρ Louis Staudt, διευθυντής του Κέντρου για τη Γονιδιωματική του Καρκίνου στο Εθνικό Ινστιτούτο Καρκίνου, δήλωσε: “Αυτός είναι ένας δυνητικά νέος τρόπος να στρέψεις τον καρκίνο εναντίον του εαυτού του”. Ο Staudt έγραψε έναν πρόλογο για να συνοδεύσει την εργασία του Crabtree. Μόλις η θεραπεία αναπτυχθεί περαιτέρω, πρόσθεσε, “θα ήθελα πολύ να τη δοκιμάσω σε μια κλινική δοκιμή με ασθενείς μας που έχουν εξαντλήσει όλες τις άλλες επιλογές”.
Σε εργαστηριακά πειράματα με κύτταρα από καρκίνο του αίματος, ένα διάχυτο μεγάλο λέμφωμα Β-κυττάρων, οι ερευνητές σχεδίασαν και κατασκεύασαν μόρια που συνδέουν δύο πρωτεΐνες: το BCL6, μια μεταλλαγμένη πρωτεΐνη στην οποία βασίζεται ο καρκίνος για να επιβιώσει και να αναπτυχθεί επιθετικά, και μια φυσιολογική κυτταρική πρωτεΐνη που ενεργοποιεί τα γονίδια τα οποία πλησιάζει.
Η νέα κατασκευή, ένα μόριο σε σχήμα αλτήρα, δεν μοιάζει με οτιδήποτε εμφανίζεται στη φύση. Το BCL6, στο ένα άκρο του αλτήρα, οδηγεί το μόριο προς τα γονίδια κυτταρικού θανάτου που αποτελούν μέρος του DNA κάθε κυττάρου και χρησιμοποιούνται για την απαλλαγή από κύτταρα που δεν χρειάζονται πλέον. Αλλά όταν ένα άτομο έχει διάχυτο μεγάλο λέμφωμα Β-κυττάρων, το BCL6 έχει απενεργοποιήσει αυτά τα γονίδια κυτταρικού θανάτου, καθιστώντας τα κύτταρα ουσιαστικά αθάνατα.
Όταν ο αλτήρας, καθοδηγούμενος από το BCL6, πλησιάζει τα γονίδια του κυτταρικού θανάτου, η κανονική πρωτεΐνη στο άκρο του αλτήρα οπλίζει αυτά τα γονίδια. Σε αντίθεση με άλλες διεργασίες στο κύτταρο που μπορούν να αντιστραφούν, η ενεργοποίηση των γονιδίων του κυτταρικού θανάτου είναι μη αναστρέψιμη. Η νέα προσέγγιση θα μπορούσε να αποτελεί πρόοδο στο δύσκολο έργο της χρήσης φαρμάκων για τον αποκλεισμό όλων των μορίων BCL6. Με τα μόρια σε σχήμα αλτήρα, αρκεί να αναπρογραμματιστεί μόνο ένα υποσύνολο των μορίων BCL6 προκειμένου να σκοτωθούν τα κύτταρα.
Η ιδέα θα μπορούσε ενδεχομένως να λειτουργήσει για τους μισούς από όλους τους καρκίνους, οι οποίοι έχουν γνωστές μεταλλάξεις που οδηγούν σε πρωτεΐνες που υποβοηθούν την ανάπτυξη, υποστήριξε ο Crabtree. Και επειδή η θεραπεία βασίζεται στις μεταλλαγμένες πρωτεΐνες που παράγονται από τα καρκινικά κύτταρα, θα μπορούσε να είναι εξαιρετικά συγκεκριμένη, διατηρώντας τα υγιή κύτταρα.
Ο Crabtree εξήγησε τους δύο τομείς έρευνας που κατέστησαν δυνατή αυτή τη μέθοδο. Ο πρώτος είναι η ανακάλυψη των “γονιδίων-οδηγών” – αρκετές εκατοντάδες γονίδια που, όταν μεταλλάσσονται, οδηγούν στην εξάπλωση του καρκίνου.
Το δεύτερο είναι η ανακάλυψη των οδών θανάτου στα κύτταρα. Αυτές οι οδοί, είπε ο Crabtree, “χρησιμοποιούνται για την εξάλειψη των κυττάρων που έχουν γίνει αδίστακτα για τον έναν ή τον άλλο λόγο” – 60 δισεκατομμύρια κύτταρα σε κάθε άτομο κάθε μέρα.
Η αποστολή ήταν να μπορούν οι οδοί που οδηγούν την ανάπτυξη των καρκινικών κυττάρων να επικοινωνούν με σιωπηλές οδούς που οδηγούν στον κυτταρικό θάνατο, κάτι που κανονικά δεν θα έκαναν.
Όταν το υβριδικό μόριο εισχώρησε στο DNA των κυττάρων, όχι μόνο ενεργοποίησε γονίδια κυτταρικού θανάτου, αλλά έκανε και περισσότερα. Το BCL6 οδήγησε το υβρίδιο σε άλλα γονίδια που ο καρκίνος είχε αποσιωπήσει. Το υβρίδιο ενεργοποίησε ξανά αυτά τα γονίδια, δημιουργώντας εσωτερικό χάος στο κύτταρο. “Το κύτταρο δεν το έχει βιώσει ποτέ αυτό”, είπε ο Staudt.
“Το BCL6 είναι η οργανωτική αρχή αυτών των καρκινικών κυττάρων”, εξήγησε. Όταν η λειτουργία του διαταράσσεται εντελώς, “το κύτταρο έχει χάσει την ταυτότητά του και λέει, “κάτι πολύ λάθος συμβαίνει εδώ. Καλύτερα να πεθάνω””.
Αλλά το κύριο αποτέλεσμα της πειραματικής θεραπείας ήταν η ενεργοποίηση των γονιδίων του κυτταρικού θανάτου, είπε ο Crabtree. “Αυτό είναι το θεραπευτικό αποτέλεσμα”, είπε.
Η ομάδα δοκίμασε το υβριδικό της μόριο σε ποντίκια, όπου και φάνηκε ασφαλές. Όμως, σημείωσε ο Staudt, “οι άνθρωποι είναι πολύ διαφορετικοί από τα ποντίκια”. Η εργασία είναι “συναρπαστική”, είπε ο Stuart Schreiber, καθηγητής χημείας και χημικής βιολογίας στο Πανεπιστήμιο του Χάρβαρντ και προηγούμενος συνεργάτης του Crabtree. Αλλά, σημείωσε, χαμηλώνοντας τον πήχη των προσδοκιών: Αυτό που δημιούργησε ο Crabtree “δεν είναι φάρμακο – έχει ακόμη πολύ δρόμο μπροστά του”.
*Η Gina Kolata είναι δημοσιογράφος των “New York Times”, με ειδίκευση σε ζητήματα ασθενειών και θεραπειών.
Το άρθρο δημοσιεύθηκε στις 7 Αυγούστου 2023 στους “New York Times”.
© 2023 The New York Times Company